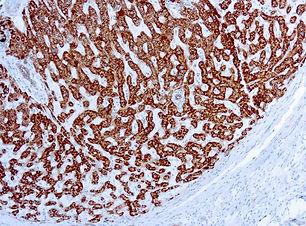
Prohibitin

top of page

Diagnostic BioSystems termékek
Lapozza fel, vagy töltse le a Diagnostic BioSystems legfrissebb katalógusát, válogasson minőségi elsődleges antitestjeik és egyéb termékeik között!
További információért és árajánlatért keressen minket bizalommal:

bottom of page